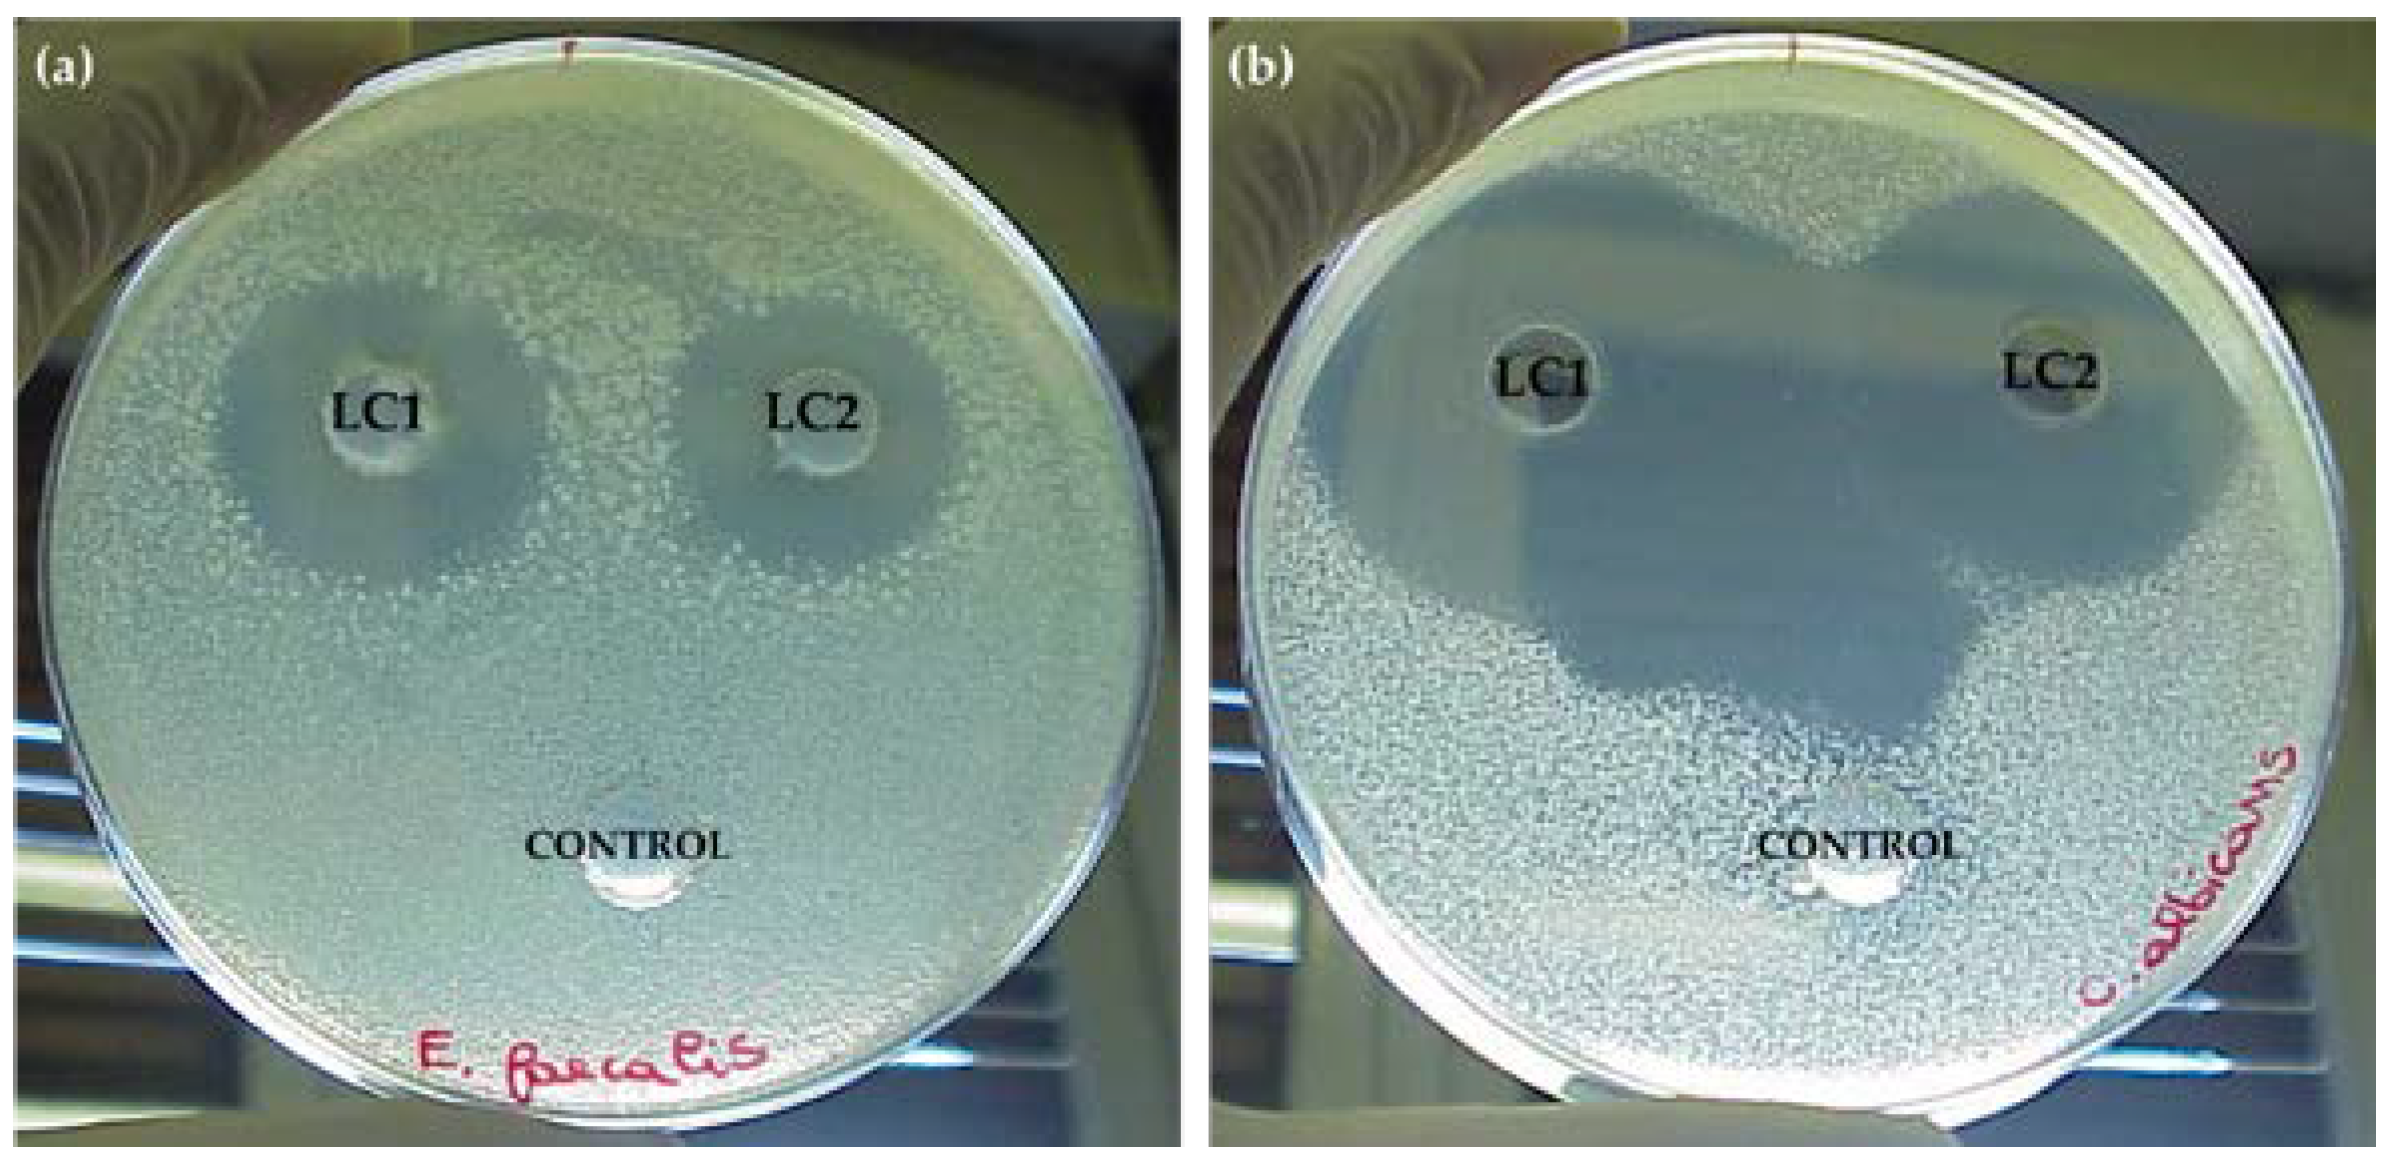
Applsci 13 01976 g001 Applsci 13 01976 g001

Lichens as a Natural Source of Compounds Active on Microorganisms of Human Health Interest
Abstract
Featured Application
Abstract
1. Introduction
2. Materials and Methods
2.1. Human Pathogens Strains and Culture Conditions
2.2. Extraction of Lichen Samples
2.3. Screening of the Antimicrobial Activity of Lichen Extracts
2.4. Fractionation of Lichen Extracts
2.5. Liquid Chromatography Mass Spectrometry Analysis
2.6. Statistical Analyses
3. Results
3.1. Extraction of Lichen Samples
3.2. Screening of the Antimicrobial Activity of Lichen Extracts
3.3. Fractionation of Lichen Extracts
3.4. Liquid Chromatography/Mass Spectrometry Analysis
4. Discussion
Author Contributions
Funding
Institutional Review Board Statement
Informed Consent Statement
Data Availability Statement
Conflicts of Interest
References
- Akhtar, N.; Ayoubi, R.; Kour, V.; Gautam, U.; Amin-ul Mannan, M. Natural products for fungal diseases management and prevention. J. Nat. Prod. 2022, 12, 60–69. [Google Scholar] [CrossRef]
- Adenubi, O.T.; Famuyide, I.M.; McGaw, L.J.; Eloff, J.N. Lichens: An update on their ethnopharmacological uses and potential as sources of drug leads. J. Ethnopharmacol. 2022, 298, 115657. [Google Scholar] [CrossRef] [PubMed]
- Hawksworth, D.; Grube, M. Lichens redefined as complex ecosystems. New Phytol. 2020, 227, 1281–1283. [Google Scholar] [CrossRef]
- Elkhateeb, W.A.; Daba, G.M.; Sheir, D.; Nguyen, T.; Hapuarachchi, K.K.; Thomas, P.W. Mysterious world of lichens: Highlights on their history, applications, and pharmaceutical potentials. Nat. Prod. J. 2021, 3, 275–287. [Google Scholar] [CrossRef]
- Girardot, M.; Millot, M.; Hamion, G.; Billard, J.L.; Juin, C.; Ntoutoume, G.M.A.N.; Sol, V.; Mambu, L.; Imbert, C. Lichen polyphenolic compounds for the eradication of Candida albicans biofilms. Front. Cell. Infect. Microbiol. 2021, 11, 698883. [Google Scholar] [CrossRef]
- Sargsyan, R.; Gasparyan, A.; Tadevosyan, G.; Panosyan, H. Antimicrobial and antioxidant potentials of non-cytotoxic extracts of corticolous lichens sampled in Armenia. AMB Express 2021, 11, 110. [Google Scholar] [CrossRef]
- Brunauer, G.; Hager, A.; Grube, M.; Türk, R.; Stocker-Wörgötter, E. Alterations in secondary metabolism of aposymbiotically grown mycobionts of Xanthoria elegans and cultured resynthesis stages. Plant Physiol. Biochem. 2007, 45, 146–151. [Google Scholar] [CrossRef]
- Elix, J.; Stocker-Wörgötter, E. Biochemistry and secondary metabolites. Lichen Biol. 1996, 1, 154–180. [Google Scholar]
- Gandhi, A.D.; Umamahesh, K.; Sathiyaraj, S.; Suriyakala, G.; Velmurugan, R.; Al Farraj, D.A.; Gawwad, M.R.A.; Murugan, K.; Babujanarthanam, R.; Saranya, R. Isolation of bioactive compounds from lichen Parmelia sulcata and evaluation of antimicrobial property. J. Infect. Public Health. 2022, 15, 491–497. [Google Scholar] [CrossRef]
- Calcott, M.J.; Ackerley, D.F.; Knight, A.; Keyzers, R.A.; Owen, J.G. Secondary metabolism in the lichen symbiosis. Chem. Soc. Rev. 2018, 47, 1730–1760. [Google Scholar] [CrossRef]
- Shukla, V.; Joshi, G.P.; Rawat, M.S.M. Lichens as a potential natural source of bioactive compounds: A review. Phytochem. Rev. 2010, 9, 303–314. [Google Scholar] [CrossRef]
- Molnár, K.; Farkas, E. Current results on biological activities of lichen secondary metabolites: A review. Z. Naturforsch. C. J. Biosci. 2010, 65, 157–173. [Google Scholar] [CrossRef]
- Jayanthi, S.; Priya, P.; Monica Devi, D.; Benila Smily, J.M. Lichens: Origin, types, secondary metabolites and applications. J. Acad. Indus. Res. 2012, 1, 45–49. [Google Scholar]
- Zambare, V.P.; Christopher, L.P. Biopharmaceutical potential of lichens. Pharm. Biol. 2012, 50, 778–798. [Google Scholar] [CrossRef]
- Maurya, I.K.; Singh, S.; Tewari, R.; Tripathi, M.; Upadhyay, S.; Joshi, Y. Antimicrobial activity of Bulbothrix setschwanensis (Zahlbr.) Hale lichen by cell wall disruption of Staphylococcus aureus and Cryptococcus neoformans. Microb. Pathog. 2018, 115, 12–18. [Google Scholar] [CrossRef]
- Shrestha, G.; St. Clair, L.L. Lichens: A promising source of antibiotic and anticancer drugs. Phytochem. Rev. 2013, 12, 229–244. [Google Scholar] [CrossRef]
- Plaza, C.M.; Salazar, C.P.; Plaza, R.E.; Vizcaya, M.; Rodriguez-Castillo, G.; Medina-Ramirez, G. In vitro analysis of antibacterial and antifungal potential of lichen species of Everniastrum cf vexans, Parmotrema blanquetianum, Parmotrema reticulatum and Peltigera laciniata. MOJ. Drug Des. Develop. Ther. 2018, 2, 125–134. [Google Scholar] [CrossRef]
- Boustie, J.; Grube, M. Lichens, a promising source of bioactive secondary metabolites. Plant. Genet. Resour. Charact. 2005, 3, 273–287. [Google Scholar] [CrossRef]
- Kokubun, T.; Shiu, W.; Gibbons, S. Inhibitory activities of lichen-derived compounds against methicillin- and multidrug-resistant Stahylococcus aureus. Planta Med. 2007, 73, 176–179. [Google Scholar] [CrossRef]
- Resende, D.I.S.P.; Pereira-Terra, P.; Inácio, Â.S.; Costa, P.M.D.; Pinto, E.; Sousa, E.; Pinto, M.M.M. Lichen Xanthones as models for new antifungal agents. Molecules. 2018, 23, 2617. [Google Scholar] [CrossRef]
- Bate, P.N.N.; Orock, A.E.; Nyongbela, K.D.; Babiaka, S.B.; Kukwah, A.; Ngemenya, M.N. In vitro activity against multi-drug resistant bacteria and cytotoxicity of lichens collected from Mount Cameroon. J. King Saud Univ. Sci. 2020, 32, 614–619. [Google Scholar] [CrossRef]
- Maciąg-Dorszyńska, M.; Węgrzyn, G.; Guzow-Krzemińska, B. Antibacterial activity of lichen secondary metabolite usnic acid is primarily caused by inhibition of RNA and DNA synthesis. FEMS Microbiol. Lett. 2014, 353, 57–62. [Google Scholar] [CrossRef] [PubMed]
- Nourbakhsh, F.; Lotfalizadeh, M.; Badpeyma, M.; Shakeri, A.; Soheili, V. From plants to antimicrobials: Natural products against bacterial membranes. Phytother. Res. 2022, 36, 33–52. [Google Scholar] [CrossRef] [PubMed]
- Dwibedi, V.; Rath, S.K. New insight into and updates on antimicrobial agents. In Emerging Modalities in Migration Antimicrobial Resistance; Akthar, N., Singh, K.S., Goyal, D., Eds.; Springer: Cham, Switzerland, 2022; pp. 179–217. [Google Scholar]
- Khameneh, B.; Iranshahy, M.; Soheil, V.; Bazzaz, B.S.F. Review on plant antimicrobials: A mechanistic viewpoint. Antimicrob. Resist. Infect. Control 2019, 8, 118. [Google Scholar] [CrossRef]
- Hemaiswarya, S.; Kruthiventi, A.K.; Doble, M. Synergism between natural products and antibiotics against infectious diseases. Phytomedicine 2008, 15, 639–652. [Google Scholar] [CrossRef]
- Chanda, S.; Rakholiya, K. Combination therapy: Synergism between natural plant extracts and antibiotics against infectious diseases. In Science against Microbial Pathogens: Communicating Current Research and Technological Advances; FORMATEX: Badajoz, Spain, 2011; Volume 1, pp. 520–529. [Google Scholar]
- Cheesman, M.J.; Ilanko, A.; Blonk, B.; Cock, I.E. Developing new antimicrobial therapies: Are synergistic combination of plants extracts/compounds with conventional antibiotics the solution? Pharmacogn. Rev. 2017, 11, 57–72. [Google Scholar] [CrossRef]
- Sarmah, A.K.; Meyer, M.T.; Boxall, A.B. A global perspective on the use, sales, exposure pathways, occurrence, fate and effects of veterinary antibiotics (VAs) in the environment. Chemosphere 2006, 65, 725–759. [Google Scholar] [CrossRef]
- Witte, W. Selective pressure by antibiotic use in livestock. Int. J. Antimicrob. Agents 2000, 16, 19–24. [Google Scholar] [CrossRef]
- Franz, C.M.; Holzapfel, W.H.; Stiles, M.E. Enterococci at the crossroads of food safety? In. J. Food Microbiol. 1999, 47, 1–24. [Google Scholar] [CrossRef]
- Denu, R.A.; Patel, D.; Becker, B.J.; Shiffler, T.; Kleinschmidt, P. MRSA septicemia with septic arthritis and prostatic, intraretinal, periapical, and lung abscesses. WMJ 2020, 119, 62–65. [Google Scholar]
- Li, X.Z.; Mehrotra, M.; Ghimire, S.; Adewoye, L. Beta-Lactam resistance and beta-lactamases in bacteria of animal origin. Vet. Microbiol. 2007, 121, 197–214. [Google Scholar] [CrossRef]
- Seiffert, S.N.; Hilty, M.; Perreten, V.; Endimiani, A. Extended-spectrum cephalosporin-resistant Gram-negative organisms in livestock: An emerging problem for human health? Drug Resist. Updat. 2013, 16, 22–45. [Google Scholar] [CrossRef]
- Schmeda-Hirschmann, G.; Tapia, A.; Lima, B.; Pertino, M.; Sortino, M.; Zacchino, S.; Arias, A.R.; Feresin, G.E. A new antifungal and antiprotozoal depside from the Andean lichen Protousnea poeppigii. Phytother. Res. 2008, 22, 349–355. [Google Scholar] [CrossRef]
- Popovici, V.; Bucur, L.; Calcan, S.I.; Cucolea, E.I.; Costache, T.; Rambu, D.; Schröder, V.; Gîrd, C.E.; Gherghel, D.; Vochita, G.; et al. Elemental analysis and in vitro evaluation of antibacterial and antifungal activities of Usnea barbata (L.) Weber ex F.H. Wigg from Călimani Mountains, Romania. Plants 2021, 11, 32. [Google Scholar] [CrossRef]
- Sun, L.; Sun, S.; Cheng, A.; Wu, X.; Zhang, Y.; Lou, H. In vitro activities of retigeric acid B alone and in combination with azole antifungal agents against Candida albicans. Antimicrob. Agents Chemother. 2009, 53, 1586–1591. [Google Scholar] [CrossRef]
- Li, Y.; Chang, W.; Zhang, M.; Li, X.; Jiao, Y.; Lou, H. Synergistic and drug-resistant reversing effects of diorcinol D combined with fluconazole against Candida albicans. FEMS Yeast Res. 2015, 15, fov001. [Google Scholar] [CrossRef]
- Zida, A.; Bamba, S.; Yacouba, A.; Ouedraogo-Traore, R.; Guiguemdé, R.T. Anti-Candida albicans natural products, sources of new antifungal drugs: A review. J. Mycol. Med. 2017, 27, 1–19. [Google Scholar] [CrossRef]
- Soxhlet, F. Die gewichtsanalytische bestimmung des milchfettes. Dinglers Polytech. J. 1879, 232, 461–465. [Google Scholar]
- Rogers, A.M.; Montville, T.J. Improved agar diffusion assay for nisin quantification. Food Biotechnol. 1991, 5, 161–168. [Google Scholar] [CrossRef]
- Olivier-Jimenez, D.; Chollet-Krugler, M.; Rondeau, D.; Beniddir, M.A.; Ferron, S.; Delhaye, T.; Allard, P.M.; Wolfender, J.L.; Sipman, H.J.M.; Lücking, R.; et al. A database of high-resolution MS/MS spectra for lichen metabolites. Sci. Data 2019, 6, 294. [Google Scholar] [CrossRef]
- Cocchietto, M.; Skert, N.; Nimis, P.L.; Sava, G. A review on usnic acid, an interesting natural compound. Naturwissenschaften 2002, 89, 137–146. [Google Scholar] [CrossRef]
- Ingólfsdóttir, K. Usnic acid. Phytochem 2002, 61, 729–736. [Google Scholar] [CrossRef]
- Moerman, K.L.; Chai, C.L.L.; Waringb, P. Evidence that the lichen-derived scabrosin esters target mitochondrial ATP-synthase in P388D1 cells. Toxicol. Appl. Pharmacol. 2003, 190, 232–240. [Google Scholar] [CrossRef]
- Waring, P.; Beaver, J. Gliotoxin and related epipolythiodioxopiperazines. Gen. Pharmacol. 1996, 27, 1311–1316. [Google Scholar] [CrossRef]
- Gardiner, D.M.; Waring, P.; Howlett, B.J. The epipolythiodioxopiperazine (ETP) class of fungal toxins: Distribution, mode of action, functions and biosynthesis. Microbiology 2005, 151, 1021–1032. [Google Scholar] [CrossRef]
- Pfaller, M.A.; Diekema, D.J. Epidemiology of invasive candidiasis: A persistent public health problem. Clin. Microbiol. Rev. 2007, 20, 133–163. [Google Scholar] [CrossRef]
- Kriengkauykiat, J.; Ito, J.I.; Dadwal, S.S. Epidemiology and treatment approaches in management of invasive fungal infections. Clin. Epidemiol. 2011, 3, 175–191. [Google Scholar] [CrossRef]
- Güvenç, A.; Akkol, E.K.; Süntar, I.; Keleş, H.; Yildiz, S.; Çaliş, I. Biological activities of Pseudevernia furfuracea (L.) Zopf extracts and isolation of the active compounds. J. Ethnopharmacol. 2012, 144, 726–734. [Google Scholar] [CrossRef]
- Türkan, M.F.; Aslan, A.; Yapici, A.N.; Meriçli Yapici, B.; Bilgi, S.T. Assessment of antimicrobial activity of natural leathers treated with Pseudevernia furfuracea (L.) Zopf extracts. Text. Appar. 2013, 23, 176–180. [Google Scholar]
- Peralta, M.A.; da Silva, M.A.; Ortega, M.G.; Cabrera, J.L.; Paraje, M.G. Usnic acid activity on oxidative and nitrosative stress of azole-resistant Candida albicans biofilm. Planta Med. 2017, 83, 326–333. [Google Scholar] [CrossRef]
- Nithyanand, P.; Beema Shafreen, R.M.; Muthamil, S.; Karutha Pandian, S. Usnic acid inhibits biofilm formation and virulent morphological traits of Candida albicans. Microbiol. Res. 2015, 179, 20–28. [Google Scholar] [CrossRef]
- Armstrong, R.A. The influence of environmental factors on the growth of lichens in the field. In Recent Advances in Lichenology; Upreti, D.K., Shukla, V., Divakar, P.K., Bajpai, R., Eds.; Springer: New Delhi, India, 2015; pp. 1–18. [Google Scholar] [CrossRef]
- Singh, G.; Calchera, A.; Schulz, M.; Drechsler, M.; Bode, H.B.; Schmitt, I.; Dal Grande, F. Climate-specific biosynthetic gene clusters in populations of a lichen-forming fungus. Environ. Microbiol. 2021, 23, 4260–4275. [Google Scholar] [CrossRef] [PubMed]
- Shukla, V.; Patel, D.K.; Bajpai, R.; Semwal, M.; Upreti, D.K. Ecological implication of variation in the secondary metabolites in Parmelioid lichens with respect to altitude. Environ. Sci. Pollut. Res. Int. 2016, 23, 1391–1397. [Google Scholar] [CrossRef]
- Bjerke, J.W.; Elvebakk, A.; Domínguez, E.; Dahlback, A. Seasonal trends in usnic acid concentrations of Arctic, alpine and Patagonian populations of the lichen Flavocetraria nivalis. Phytochemistry 2005, 66, 337–344. [Google Scholar] [CrossRef]

| LC1 | LC2 | |||||||
|---|---|---|---|---|---|---|---|---|
| 1 d | 7 d | 15 d | 30 d | 1 d | 7 d | 15 d | 30 d | |
| Staphylococcus aureus ATCC 6538 | 8 ± 2 | 4 ± 0.5 a | 0 b | 0 b | 8 ± 1 | 3 ± 1.5 b | 0 b | 0 b |
| Enterococcus faecalis ATCC 29212 | 24 ± 2 | 24 ± 1 | 0 d | 0 d | 24 ± 0.5 | 22 ± 1 | 0 d | 0 d |
| Bacillus subtilis ATCC 6633 | 16 ± 2 | 15 ± 1 | 0 c | 0 c | 16 ± 0.5 | 14 ± 1 | 0 c | 0 c |
| Escherichia coli ATCC 8739 | 24 ± 0.5 | 0 d | 0 d | 0 d | 24 ± 1.5 | 0 d | 0 d | 0 d |
| Pseudomonas aeruginosa ATCC 27853 | 22 ± 2 | 0 d | 0 d | 0 d | 22 ± 1 | 0 d | 0 d | 0 d |
| Burkholderia cepacia MM 08 | 6 ± 1 | 0 d | 0 d | 0 d | 6 ± 2 | 0 d | 0 d | 0 d |
| Klebsiella pneumoniae MM 01 | 12 ± 0.5 | 0 d | 0 d | 0 d | 12 ± 2.5 | 0 d | 0 d | 0 d |
| Candida albicans ATCC 10231 | 40 ± 2 | 40 ± 3 | 39 ± 0.5 | 38 ± 3 | 40 ± 1 | 40 ± 1 | 37 ± 2 | 37 ± 1 |
| Lichen Extracts | Solvent | % Yield | Main Matabolites |
|---|---|---|---|
| LC1 | Cyclohexane | 1.0 | variolatic acid scabrosin derivates |
| LC2 | Acetone | 2.4 | variolatic acid scabrosin derivates |
Disclaimer/Publisher’s Note: The statements, opinions and data contained in all publications are solely those of the individual author(s) and contributor(s) and not of MDPI and/or the editor(s). MDPI and/or the editor(s) disclaim responsibility for any injury to people or property resulting from any ideas, methods, instructions or products referred to in the content. |
© 2023 by the authors. Licensee MDPI, Basel, Switzerland. This article is an open access article distributed under the terms and conditions of the Creative Commons Attribution (CC BY) license (https://creativecommons.org/licenses/by/4.0/).
Share and Cite
Condò, C.; Anfelli, I.; Forti, L.; Sabia, C.; Messi, P.; Iseppi, R. Lichens as a Natural Source of Compounds Active on Microorganisms of Human Health Interest. Appl. Sci. 2023, 13, 1976. https://doi.org/10.3390/app13031976
Condò C, Anfelli I, Forti L, Sabia C, Messi P, Iseppi R. Lichens as a Natural Source of Compounds Active on Microorganisms of Human Health Interest. Applied Sciences. 2023; 13(3):1976. https://doi.org/10.3390/app13031976
Chicago/Turabian StyleCondò, Carla, Igor Anfelli, Luca Forti, Carla Sabia, Patrizia Messi, and Ramona Iseppi. 2023. "Lichens as a Natural Source of Compounds Active on Microorganisms of Human Health Interest" Applied Sciences 13, no. 3: 1976. https://doi.org/10.3390/app13031976
APA StyleCondò, C., Anfelli, I., Forti, L., Sabia, C., Messi, P., & Iseppi, R. (2023). Lichens as a Natural Source of Compounds Active on Microorganisms of Human Health Interest. Applied Sciences, 13(3), 1976. https://doi.org/10.3390/app13031976












